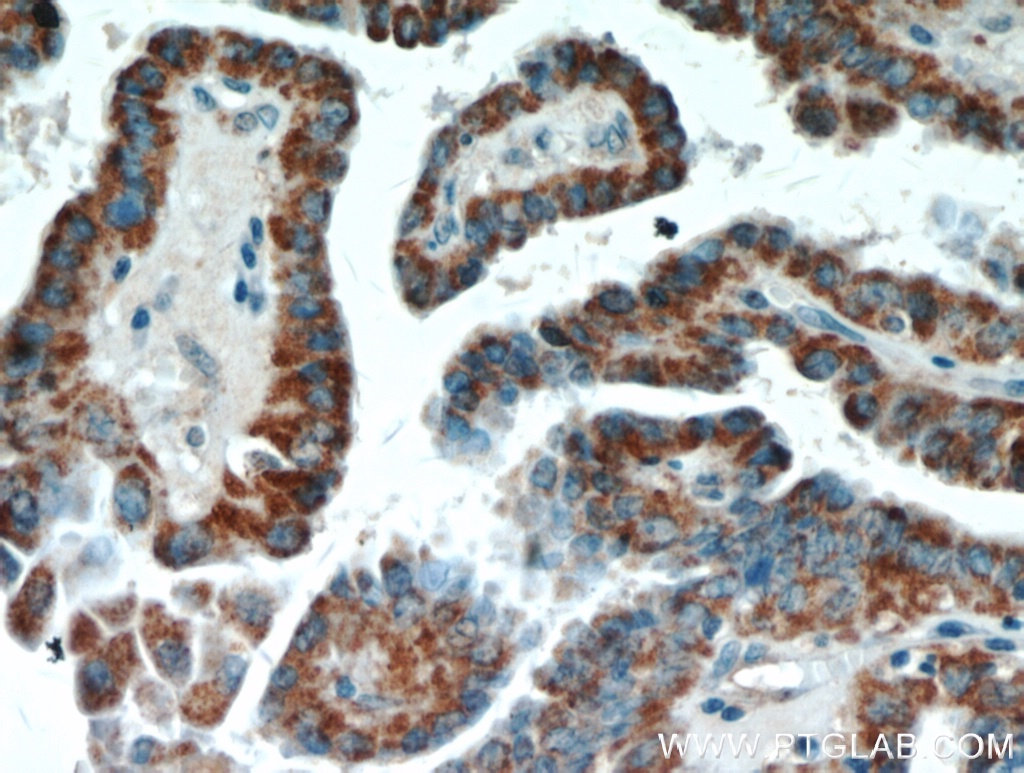

验证数据展示
经过测试的应用
| Positive WB detected in | A549 cells, L02 cells, HepG2 cells, mouse liver tissue, mouse kidney tissue, MCF-7 cells, mouse pancreas tissue, rat pancreas tissue, A375 cells |
| Positive IHC detected in | human thyroid cancer tissue, human breast cancer tissue, human lung cancer tissue, human pancreas cancer tissue Note: suggested antigen retrieval with TE buffer pH 9.0; (*) Alternatively, antigen retrieval may be performed with citrate buffer pH 6.0 |
| Positive IF/ICC detected in | HepG2 cells |
推荐稀释比
| 应用 | 推荐稀释比 |
|---|---|
| Western Blot (WB) | WB : 1:500-1:2000 |
| Immunohistochemistry (IHC) | IHC : 1:100-1:400 |
| Immunofluorescence (IF)/ICC | IF/ICC : 1:50-1:500 |
| It is recommended that this reagent should be titrated in each testing system to obtain optimal results. | |
| Sample-dependent, Check data in validation data gallery. | |
产品信息
11521-1-AP targets ECM1 in WB, IHC, IF/ICC, IP, ELISA applications and shows reactivity with human, mouse, rat samples.
| 经测试应用 | WB, IHC, IF/ICC, ELISA Application Description |
| 文献引用应用 | WB, IHC, IF, IP |
| 经测试反应性 | human, mouse, rat |
| 文献引用反应性 | human, mouse, canine |
| 免疫原 |
CatNo: Ag2084 Product name: Recombinant human ECM1 protein Source: e coli.-derived, PGEX-4T Tag: GST Domain: 241-540 aa of BC023505 Sequence: MSRFCEAEFSVKTRPHWCCTRQGEARFSCFQEEAPQPHYQLRACPSHQPDISSGLELPFPPGVPTLDNIKNICHLRRFRSVPRNLPATDPLQRELLALIQLEREFQRCCRQGNNHTCTWKAWEDTLDKYCDREYAVKTHHHLCCRHPPSPTRDECFARRAPYPNYDRDILTIDISRVTPNLMGHLCGNQRVLTKHKHIPGLIHNMTARCCDLPFPEQACCAEEEKLTFINDLCGPRRNIWRDPALCCYLSPGDEQVNCFNINYLRNVALVSGDTENAKGQGEQGSTGGTNISSTSEPKEE 种属同源性预测 |
| 宿主/亚型 | Rabbit / IgG |
| 抗体类别 | Polyclonal |
| 产品类型 | Antibody |
| 全称 | extracellular matrix protein 1 |
| 别名 | extracellular matrix protein 1, Secretory component p85 |
| 计算分子量 | 540 aa, 61 kDa |
| 观测分子量 | 55-61 kDa |
| GenBank蛋白编号 | BC023505 |
| 基因名称 | ECM1 |
| Gene ID (NCBI) | 1893 |
| RRID | AB_2261964 |
| 偶联类型 | Unconjugated |
| 形式 | Liquid |
| 纯化方式 | Antigen affinity purification |
| UNIPROT ID | Q16610 |
| 储存缓冲液 | PBS with 0.02% sodium azide and 50% glycerol, pH 7.3. |
| 储存条件 | Store at -20°C. Stable for one year after shipment. Aliquoting is unnecessary for -20oC storage. |
背景介绍
Extracellular matrix protein 1 (ECM1) is a glycoprotein involved in a number of biological processes such as bone formation, skin differentiation, cell proliferation, and promotes angiostasis.ECM1 is expressed in breast cancer and could participate in cell migration and angiogenesis. Pathologically, ECM1 contributes to the formation and metastasis of several types of cancer including breast, thyroid and hepatocellular cancers.(PMID:21128013) It inhibits MMP9 proteolytic activity. ECM1 protein is a possible trigger for angiogenesis, tumor progression and malignancies(PMID:21497598).
实验方案
| Product Specific Protocols | |
|---|---|
| IF protocol for ECM1 antibody 11521-1-AP | Download protocol |
| IHC protocol for ECM1 antibody 11521-1-AP | Download protocol |
| WB protocol for ECM1 antibody 11521-1-AP | Download protocol |
| Standard Protocols | |
|---|---|
| Click here to view our Standard Protocols |
发表文章
| Species | Application | Title |
|---|---|---|
Cancer Lett Liver metastasis or peritoneal metastasis: single-cell RNA sequencing reveals the organotropism in colorectal cancer is driven by distinct partial-EMT processes | ||
Dev Cell Spatial Control of Primary Ciliogenesis by Subdistal Appendages Alters Sensation-Associated Properties of Cilia. | ||
Cell Mol Life Sci Crip2 affects vascular development by fine-tuning endothelial cell aggregation and proliferation | ||
Oncogene Extracellular matrix protein 1 promotes cell metastasis and glucose metabolism by inducing integrin β4/FAK/SOX2/HIF-1α signaling pathway in gastric cancer. | ||
J Biol Chem Phospholipid scramblase 1 is secreted by a lipid raft-dependent pathway and interacts with the extracellular matrix protein 1 in the dermal epidermal junction zone of human skin. | ||
Am J Transl Res miR-23a-5p inhibits cell proliferation and invasion in pancreatic ductal adenocarcinoma by suppressing ECM1 expression. |